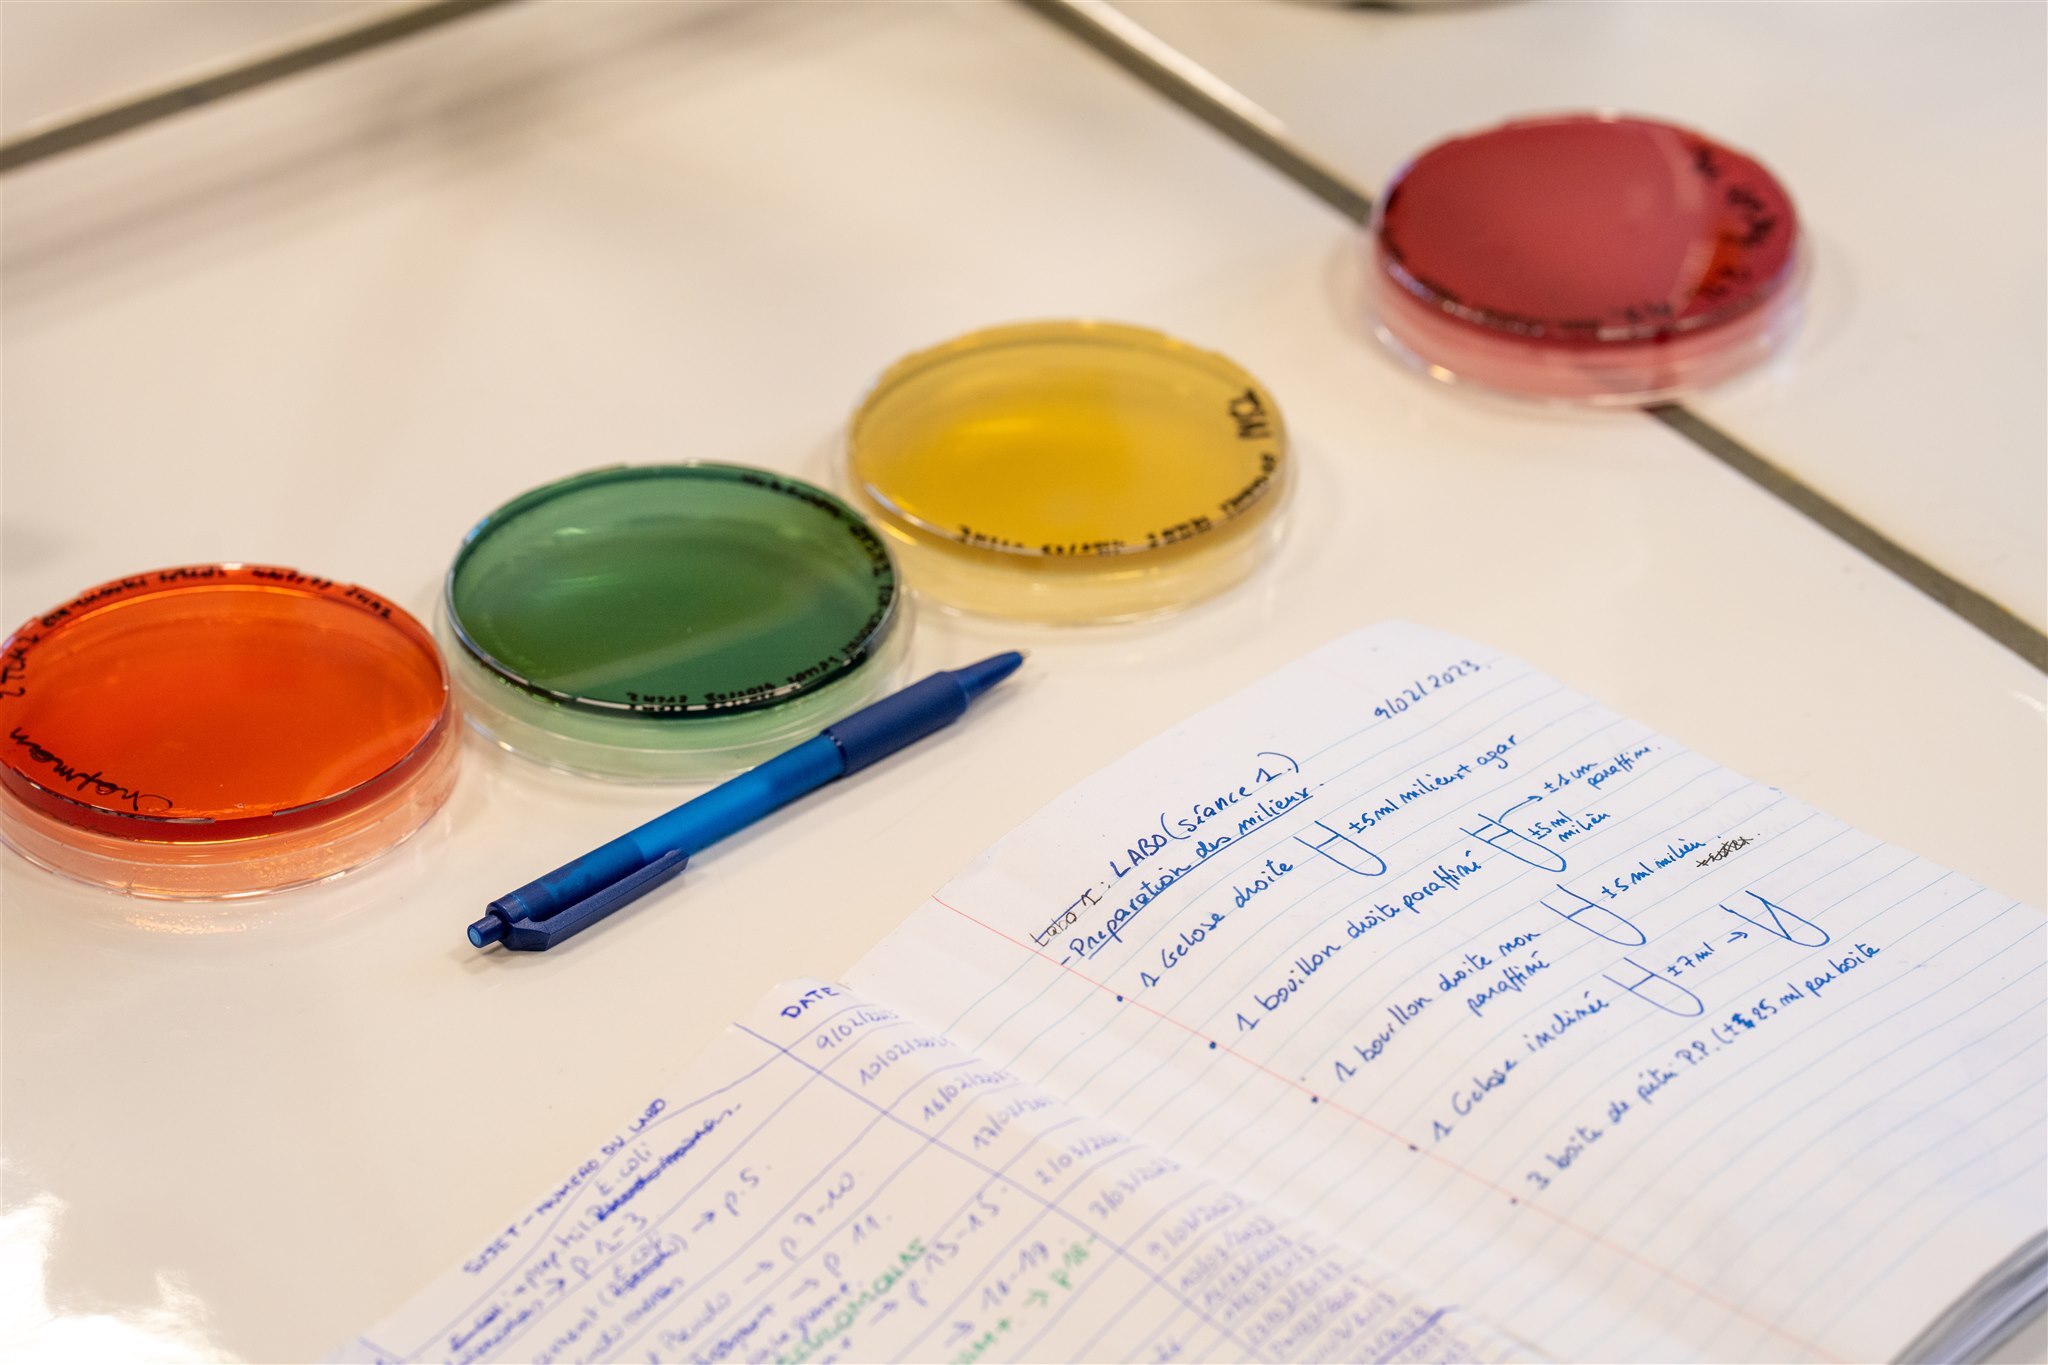
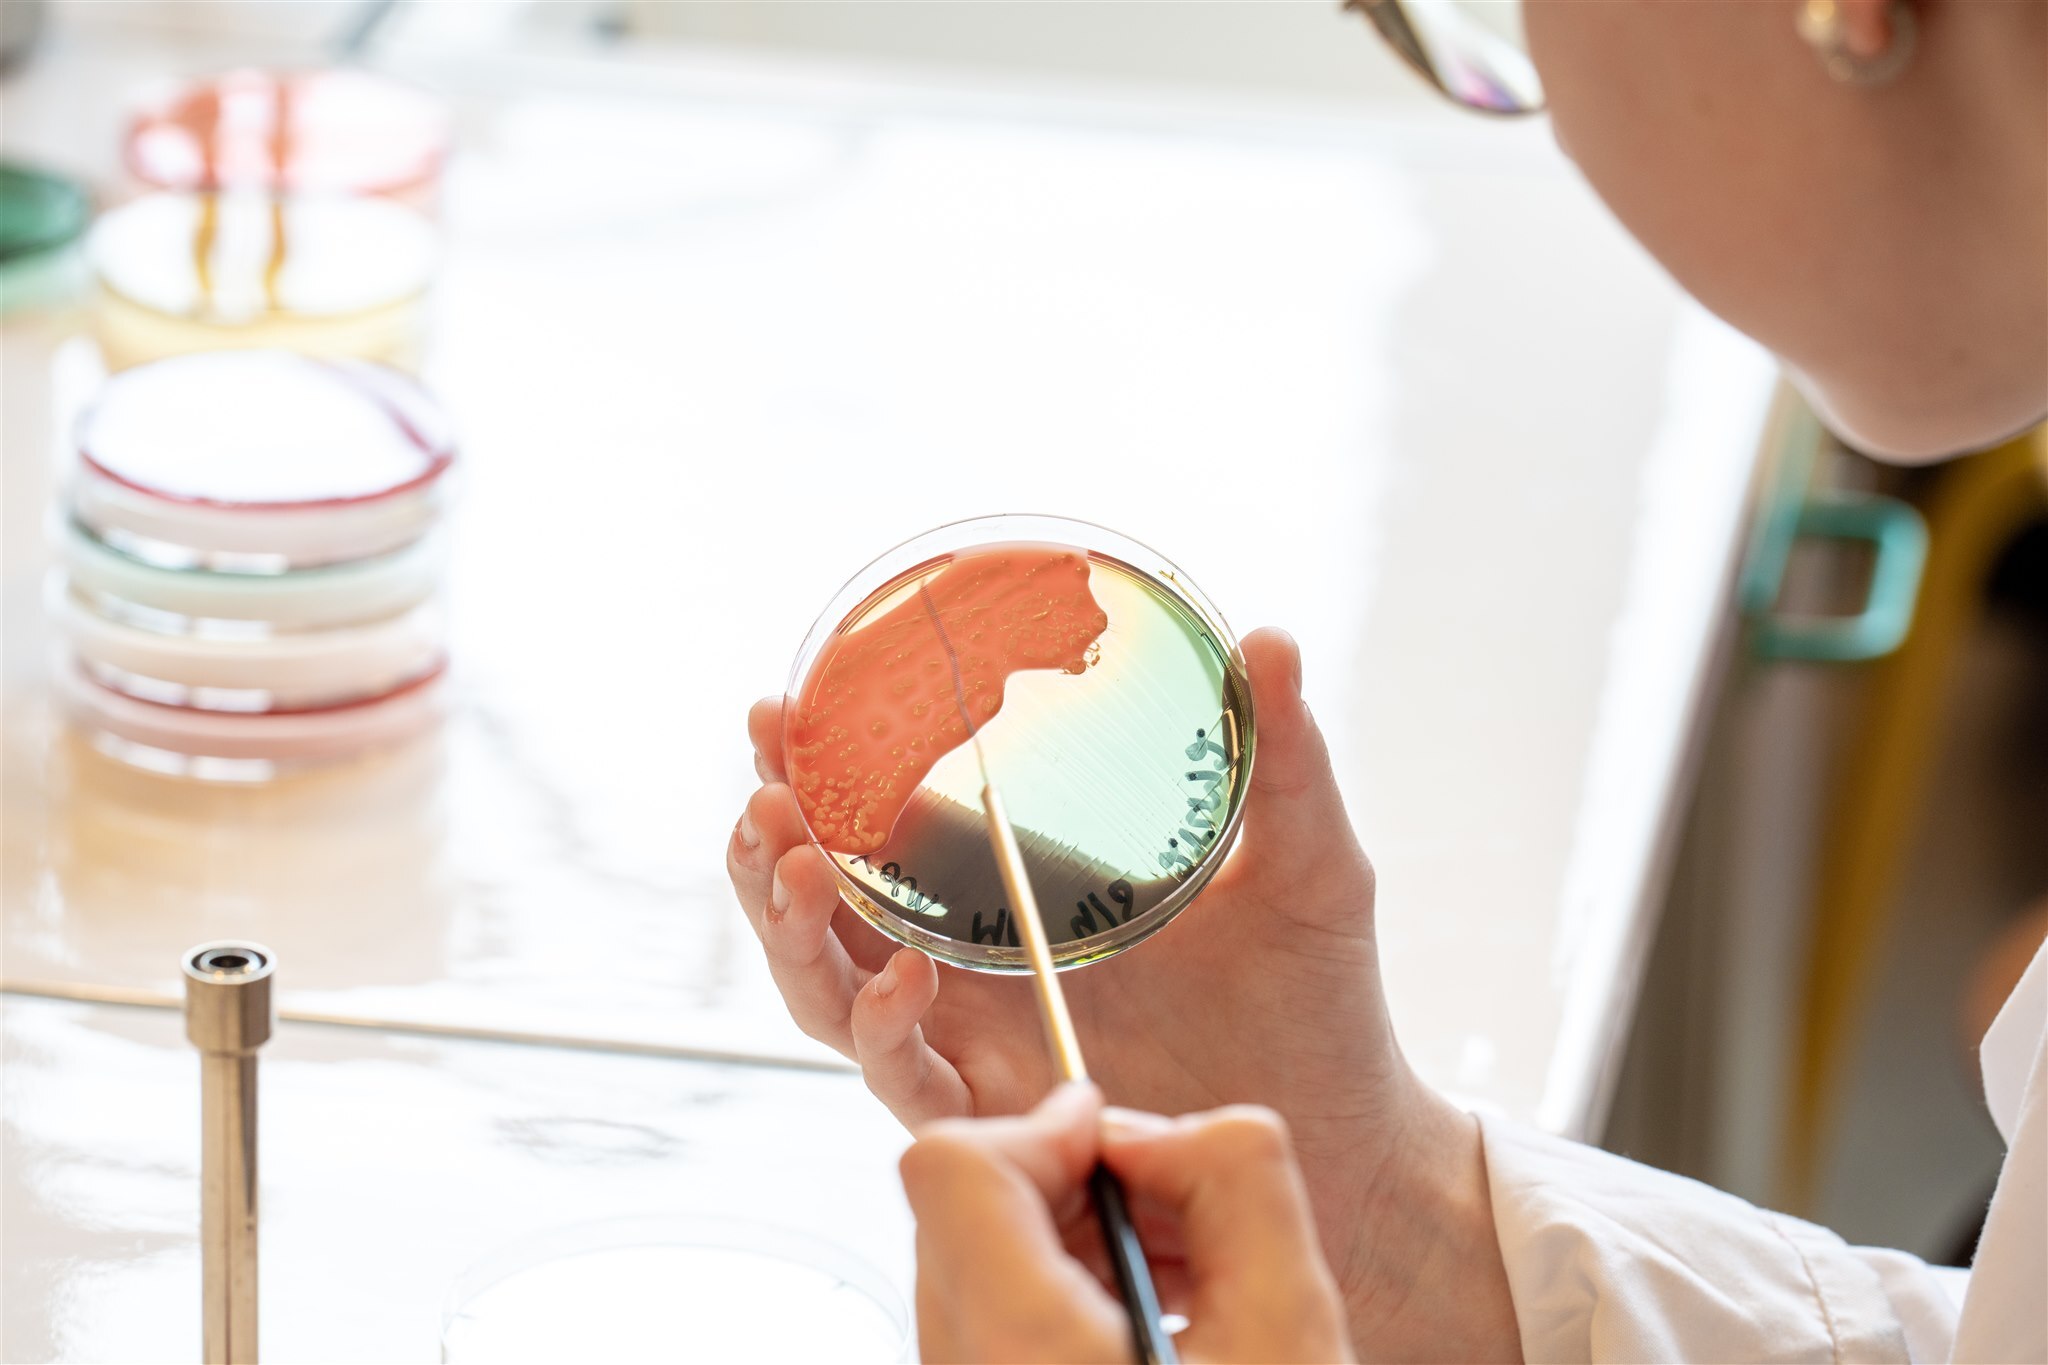

Bachelier Technologue de laboratoire médical
- Type d’études
- Bachelier
- Durée
- 3 ans
- Horaire
- En journée
- Nombre de crédits
- 180 crédits
- Département
- Paramédical
- Domaines
- Sciences biomédicales & pharmaceutiques

En bref
Devenir Technologue de laboratoire médical
Option chimie clinique

Une étudiante Technologue lors d'un cours de laboratoire de chimie
Le technologue de laboratoire médical assure la mise au point et l’exécution d’examens de laboratoire in vitro sur des échantillons d’origine humaine (tels que sang, urine,…) et d’examens in vivo afin d’évaluer certaines fonctions biologiques de patients. Le technologue assure le bon fonctionnement du matériel d’analyse et veille à la validité des données médicales. Il contribue ainsi à un diagnostic fiable.
HELMo Sainte-Julienne offre aux futurs étudiants une formation à fort contenu technologique qui permettra à ses diplômés de s’intégrer tant dans des laboratoires d’analyses médicales (privés ou hospitaliers) que dans des secteurs tels que les biotechnologies et la recherche biomédicale fondamentale ou appliquée.
Le programme d’études supérieures en technologue de laboratoire médical comprend un enseignement théorique et pratique articulé autour des domaines suivants : les sciences biomédicales, les sciences chimiques, les sciences mathématiques et physiques, les compétences transversales et la pratique professionnelle.
Points forts
- Le bachelier a été audité par l'Agence pour l'Evaluation de la Qualité de l'Enseignement supérieur (AEQES)
- Un ensemble d’Activités d’Intégration Professionnelle (AIP) telles que des séminaires, des stages préparatoires, des visites de laboratoire
- Une approche pédagogique est essentiellement pratique
- Mise en situation professionnelle réelle.
- Des classes équipées de matériel à la pointe
- Un équipement de préparation et d’analyse des échantillons biologiques, important et diversifié
- Grâce à ce matériel, les étudiants et l’équipe pédagogique participent à certains programmes de recherche (Beware, INTERREG EMR, chèques technologiques,...)
- Des évaluations formatives et continues
- Des outils d’apprentissage interactifs tels que le Laboratoire Virtuel, Log-In, HELMo-Learn,…
- Le coaching inter-départements
La formation de bachelier Technologue de laboratoire médical en images :
Carousel d’images
Formation
Projet pédagogique
Tout au long du cursus en enseignement supérieur, l'approche pédagogique est essentiellement pratique, basée sur la réalisation d’exercices, de séances de laboratoire ainsi que des stages plaçant ainsi les étudiants en situation professionnelle réelle.
Au premier quadrimestre du Bloc 1, l’accent est mis sur une mise à niveau des sciences fondamentales à savoir la biologie, la chimie, les mathématiques et la physique ainsi qu’un apprentissage des techniques de base de laboratoire. Le deuxième quadrimestre du Bloc 1 est dédié à une introduction aux sciences biomédicales (hématologie, cyto-histologie, microbiologie et chimie clinique).
En bloc 2, le programme est essentiellement orienté vers les sciences biomédicales et professionnelles ainsi qu’à une première rencontre avec les laboratoires professionnels d’analyses médicales lors d’un stage.
Le premier quadrimestre du bloc 3 est consacré à l’introduction de nouvelles spécialisations dans les sciences biomédicales et professionnelles. Enfin, le deuxième quadrimestre du bloc 3 est entièrement centré sur la réalisation des stages cliniques dans les laboratoires d’analyses médicales et de travail de fin d’études dans les laboratoires de recherche ou d’analyses médicales.
Carousel d’images
Stages & Activités d'immersion professionnelle
Le cursus en études supérieure Technologue de laboratoire médical propose un ensemble d’Activités d’Intégration Professionnelle (AIP) telles que des séminaires, des stages préparatoires, des visites de laboratoire, des stages cliniques et de travail de fin d’étude.
342 heures de stage dans minimum trois des domaines suivants : chimie clinique, hématologie, microbiologie, cyto(histo)logie/anatomie-pathologique, génétique humaine, matériel corporel humain et tests fonctionnels. Ces stages sont réalisés dans des laboratoires d’analyses médicales, hors institut, durant les blocs 2 et 3 et s’accompagnent de la réalisation d’un portfolio.
266 heures de stage dans le domaine médical au choix. Ce stage donne lieu à la rédaction d’un travail de fin d’études, sa présentation et sa défense devant un jury.
Portraits
Ils vous parlent de la formation :
Portraits mis en avant
-
Julie Craps, Enseignant·e 
-
Annabelle Lejeune, Enseignant·e 
-
Sonia El Guendi, Enseignant·e 
Liens utiles
Matériels éducatifs pour les étudiants
Hôpital virtuel
Innovation pédagogique pour des situations d’apprentissages quasi réelles…

Bientôt deux nouveaux bacheliers en alternance
La chimie, la biologie et leur application dans l’industrie t’intéressent ? Tu veux comprendre le fonctionnement des laboratoires, des chaînes de production et des processus de contrôle des produits ?
Avec notre nouvelle offre de BACHELIERS EN ALTERNANCE en Bioqualité et Biopharmaceutique, tu bénéficieras d’un apprentissage alliant théorie et immersion en entreprise. Grâce à cette approche, tu développeras des compétences concrètes tout en étant directement confronté aux réalités du terrain. Si apprendre en pratiquant te motive, ces formations sont faites pour toi !